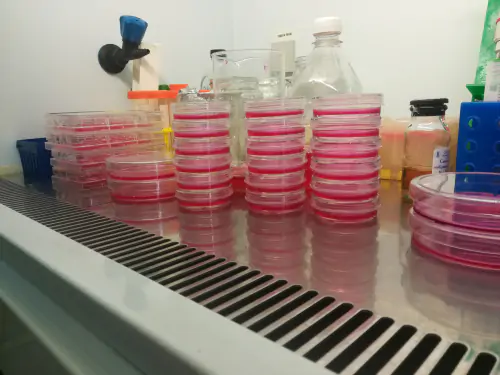
Department of Chemical Carcinogenesis

Максимова Варвара Павловна
О себе
Сотрудник лаборатории канцерогенных веществ отдела химического канцерогенеза НИИ канцерогенеза НМИЦ онкологии им. Н.Н. Блохина.
Лаборатория занимается исследованиями в области химического канцерогенеза и эпигенетики. Основные темы:
1) Анализ эпигенетической активности ксенобиотиков (канцерогены, пестициды, противоопухолевые препараты)
2) Детализация механизмов действия эпигенетически активных ксенобиотиков
) Разработка подходов к совершенствованию химиотерапии опухолей с эпигенетически аберрантным фенотипом
4) Создание и валидация тест-системы для анализа эпигенетической активности потенциальных канцерогенов
5) Создание тест-системы для выявления изменений экспрессии генов ключевых процессов канцерогенеза при действии негенотоксичных ксенобиотиков
6) Анализ молекулярного механизма действия потенциально канцерогенно-опасных пестицидов
Лаборатории
Образование
Топ-100
Области наук
|
1
2
3
4
5
6
7
8
|
|
|
Cancer Research
|
Cancer Research, 8, 21.62%
Cancer Research
8 публикаций, 21.62%
|
|
Oncology
|
Oncology, 6, 16.22%
Oncology
6 публикаций, 16.22%
|
|
Organic Chemistry
|
Organic Chemistry, 4, 10.81%
Organic Chemistry
4 публикации, 10.81%
|
|
Drug Discovery
|
Drug Discovery, 3, 8.11%
Drug Discovery
3 публикации, 8.11%
|
|
Physical and Theoretical Chemistry
|
Physical and Theoretical Chemistry, 3, 8.11%
Physical and Theoretical Chemistry
3 публикации, 8.11%
|
|
Pharmaceutical Science
|
Pharmaceutical Science, 3, 8.11%
Pharmaceutical Science
3 публикации, 8.11%
|
|
Biochemistry
|
Biochemistry, 2, 5.41%
Biochemistry
2 публикации, 5.41%
|
|
Inorganic Chemistry
|
Inorganic Chemistry, 2, 5.41%
Inorganic Chemistry
2 публикации, 5.41%
|
|
General Medicine
|
General Medicine, 2, 5.41%
General Medicine
2 публикации, 5.41%
|
|
Molecular Medicine
|
Molecular Medicine, 2, 5.41%
Molecular Medicine
2 публикации, 5.41%
|
|
Analytical Chemistry
|
Analytical Chemistry, 2, 5.41%
Analytical Chemistry
2 публикации, 5.41%
|
|
Chemistry (miscellaneous)
|
Chemistry (miscellaneous), 2, 5.41%
Chemistry (miscellaneous)
2 публикации, 5.41%
|
|
Pharmacology, Toxicology and Pharmaceutics (miscellaneous)
|
Pharmacology, Toxicology and Pharmaceutics (miscellaneous), 2, 5.41%
Pharmacology, Toxicology and Pharmaceutics (miscellaneous)
2 публикации, 5.41%
|
|
Genetics (clinical)
|
Genetics (clinical), 2, 5.41%
Genetics (clinical)
2 публикации, 5.41%
|
|
Biochemistry (medical)
|
Biochemistry (medical), 2, 5.41%
Biochemistry (medical)
2 публикации, 5.41%
|
|
Catalysis
|
Catalysis, 1, 2.7%
Catalysis
1 публикация, 2.7%
|
|
Computer Science Applications
|
Computer Science Applications, 1, 2.7%
Computer Science Applications
1 публикация, 2.7%
|
|
Spectroscopy
|
Spectroscopy, 1, 2.7%
Spectroscopy
1 публикация, 2.7%
|
|
Molecular Biology
|
Molecular Biology, 1, 2.7%
Molecular Biology
1 публикация, 2.7%
|
|
Pharmacology
|
Pharmacology, 1, 2.7%
Pharmacology
1 публикация, 2.7%
|
|
Biophysics
|
Biophysics, 1, 2.7%
Biophysics
1 публикация, 2.7%
|
|
Multidisciplinary
|
Multidisciplinary, 1, 2.7%
Multidisciplinary
1 публикация, 2.7%
|
|
Food Science
|
Food Science, 1, 2.7%
Food Science
1 публикация, 2.7%
|
|
Geriatrics and Gerontology
|
Geriatrics and Gerontology, 1, 2.7%
Geriatrics and Gerontology
1 публикация, 2.7%
|
|
Biochemistry, Genetics and Molecular Biology (miscellaneous)
|
Biochemistry, Genetics and Molecular Biology (miscellaneous), 1, 2.7%
Biochemistry, Genetics and Molecular Biology (miscellaneous)
1 публикация, 2.7%
|
|
1
2
3
4
5
6
7
8
|
Журналы
|
1
2
3
4
5
6
|
|
|
Siberian Journal of Oncology
6 публикаций, 16.22%
|
|
|
Advances in molecular oncology
6 публикаций, 16.22%
|
|
|
Molecules
3 публикации, 8.11%
|
|
|
Preprints.org
2 публикации, 5.41%
|
|
|
Biochemistry (Moscow)
1 публикация, 2.7%
|
|
|
Pharmaceutics
1 публикация, 2.7%
|
|
|
Bioinorganic Chemistry and Applications
1 публикация, 2.7%
|
|
|
Current Pharmaceutical Design
1 публикация, 2.7%
|
|
|
Cancer Prevention Research
1 публикация, 2.7%
|
|
|
International Journal of Molecular Sciences
1 публикация, 2.7%
|
|
|
Foods and Raw Materials
1 публикация, 2.7%
|
|
|
Cancers
1 публикация, 2.7%
|
|
|
PLoS ONE
1 публикация, 2.7%
|
|
|
Cells
1 публикация, 2.7%
|
|
|
Epigenomes
1 публикация, 2.7%
|
|
|
1
2
3
4
5
6
|
Цитирующие журналы
Издатели
|
2
4
6
8
10
|
|
|
MDPI
10 публикаций, 27.03%
|
|
|
Tomsk Cancer Research Institute
6 публикаций, 16.22%
|
|
|
Publishing House ABV Press
6 публикаций, 16.22%
|
|
|
Bentham Science Publishers Ltd.
1 публикация, 2.7%
|
|
|
Pleiades Publishing
1 публикация, 2.7%
|
|
|
Public Library of Science (PLoS)
1 публикация, 2.7%
|
|
|
American Association for Cancer Research (AACR)
1 публикация, 2.7%
|
|
|
Kemerovo State University
1 публикация, 2.7%
|
|
|
Hindawi Limited
1 публикация, 2.7%
|
|
|
2
4
6
8
10
|
Организации из публикаций
|
5
10
15
20
25
|
|
|
Национальный медицинский исследовательский центр онкологии им. Н. Н. Блохина Минздрава России
23 публикации, 62.16%
|
|
|
Российский Университет Дружбы Народов
19 публикаций, 51.35%
|
|
|
Организация не определена
|
Организация не определена, 14, 37.84%
Организация не определена
14 публикаций, 37.84%
|
|
Первый Московский государственный медицинский университет имени И. М. Сеченова
11 публикаций, 29.73%
|
|
|
Рязанский государственный медицинский университет имени академика И. П. Павлова
11 публикаций, 29.73%
|
|
|
МИРЭА — Российский технологический университет
10 публикаций, 27.03%
|
|
|
Российский химико-технологический университет имени Д. И. Менделеева
3 публикации, 8.11%
|
|
|
Московский государственный университет имени М.В. Ломоносова
2 публикации, 5.41%
|
|
|
Федеральный исследовательский центр химической физики им. Н.Н. Семёнова РАН
2 публикации, 5.41%
|
|
|
Российский национальный исследовательский медицинский университет имени Н. И. Пирогова
2 публикации, 5.41%
|
|
|
Институт органической химии им. Н.Д. Зелинского РАН
1 публикация, 2.7%
|
|
|
Национальный исследовательский университет «Высшая школа экономики»
1 публикация, 2.7%
|
|
|
Национальный исследовательский ядерный университет «МИФИ»
1 публикация, 2.7%
|
|
|
Национальный исследовательский технологический университет «МИСиС»
1 публикация, 2.7%
|
|
|
Институт биохимической физики им. Н.М. Эмануэля РАН
1 публикация, 2.7%
|
|
|
Институт химии Коми НЦ УрО РАН
1 публикация, 2.7%
|
|
|
Самарский государственный технический университет
1 публикация, 2.7%
|
|
|
Научно-исследовательский институт по изысканию новых антибиотиков имени Г.Ф. Гаузе
1 публикация, 2.7%
|
|
|
Государственный научно-исследовательский институт химии и технологии элементоорганических соединений
1 публикация, 2.7%
|
|
|
Сыктывкарский государственный университет имени Питирима Сорокина
1 публикация, 2.7%
|
|
|
Университет Восточного Пьемонта «Амедео Авогадро»
1 публикация, 2.7%
|
|
|
Университет Тафтса
1 публикация, 2.7%
|
|
|
Вюрцбургский университет имени Юлиуса Максимилиана
1 публикация, 2.7%
|
|
|
Венский университет
1 публикация, 2.7%
|
|
|
Онкологический центр Фокс Чейз
1 публикация, 2.7%
|
|
|
Университет Темпл
1 публикация, 2.7%
|
|
|
5
10
15
20
25
|
Страны из публикаций
|
5
10
15
20
25
30
|
|
|
Россия
|
Россия, 26, 70.27%
Россия
26 публикаций, 70.27%
|
|
Страна не определена
|
Страна не определена, 11, 29.73%
Страна не определена
11 публикаций, 29.73%
|
|
США
|
США, 4, 10.81%
США
4 публикации, 10.81%
|
|
Германия
|
Германия, 1, 2.7%
Германия
1 публикация, 2.7%
|
|
Австрия
|
Австрия, 1, 2.7%
Австрия
1 публикация, 2.7%
|
|
Италия
|
Италия, 1, 2.7%
Италия
1 публикация, 2.7%
|
|
5
10
15
20
25
30
|
Цитирующие организации
Цитирующие страны
|
10
20
30
40
50
60
|
|
|
Россия
|
Россия, 57, 43.85%
Россия
57 цитирований, 43.85%
|
|
Страна не определена
|
Страна не определена, 21, 16.15%
Страна не определена
21 цитирование, 16.15%
|
|
США
|
США, 16, 12.31%
США
16 цитирований, 12.31%
|
|
Китай
|
Китай, 11, 8.46%
Китай
11 цитирований, 8.46%
|
|
Индия
|
Индия, 8, 6.15%
Индия
8 цитирований, 6.15%
|
|
Германия
|
Германия, 6, 4.62%
Германия
6 цитирований, 4.62%
|
|
Испания
|
Испания, 6, 4.62%
Испания
6 цитирований, 4.62%
|
|
Италия
|
Италия, 4, 3.08%
Италия
4 цитирования, 3.08%
|
|
Египет
|
Египет, 3, 2.31%
Египет
3 цитирования, 2.31%
|
|
Малайзия
|
Малайзия, 3, 2.31%
Малайзия
3 цитирования, 2.31%
|
|
Саудовская Аравия
|
Саудовская Аравия, 3, 2.31%
Саудовская Аравия
3 цитирования, 2.31%
|
|
Казахстан
|
Казахстан, 2, 1.54%
Казахстан
2 цитирования, 1.54%
|
|
Польша
|
Польша, 2, 1.54%
Польша
2 цитирования, 1.54%
|
|
Финляндия
|
Финляндия, 2, 1.54%
Финляндия
2 цитирования, 1.54%
|
|
Беларусь
|
Беларусь, 1, 0.77%
Беларусь
1 цитирование, 0.77%
|
|
Бангладеш
|
Бангладеш, 1, 0.77%
Бангладеш
1 цитирование, 0.77%
|
|
Бразилия
|
Бразилия, 1, 0.77%
Бразилия
1 цитирование, 0.77%
|
|
Великобритания
|
Великобритания, 1, 0.77%
Великобритания
1 цитирование, 0.77%
|
|
Греция
|
Греция, 1, 0.77%
Греция
1 цитирование, 0.77%
|
|
Иордания
|
Иордания, 1, 0.77%
Иордания
1 цитирование, 0.77%
|
|
Иран
|
Иран, 1, 0.77%
Иран
1 цитирование, 0.77%
|
|
Марокко
|
Марокко, 1, 0.77%
Марокко
1 цитирование, 0.77%
|
|
Мексика
|
Мексика, 1, 0.77%
Мексика
1 цитирование, 0.77%
|
|
ОАЭ
|
ОАЭ, 1, 0.77%
ОАЭ
1 цитирование, 0.77%
|
|
Сингапур
|
Сингапур, 1, 0.77%
Сингапур
1 цитирование, 0.77%
|
|
Судан
|
Судан, 1, 0.77%
Судан
1 цитирование, 0.77%
|
|
Турция
|
Турция, 1, 0.77%
Турция
1 цитирование, 0.77%
|
|
Черногория
|
Черногория, 1, 0.77%
Черногория
1 цитирование, 0.77%
|
|
Швейцария
|
Швейцария, 1, 0.77%
Швейцария
1 цитирование, 0.77%
|
|
10
20
30
40
50
60
|
- Мы не учитываем публикации, у которых нет DOI.
- Статистика пересчитывается раз в сутки.

















































































































































